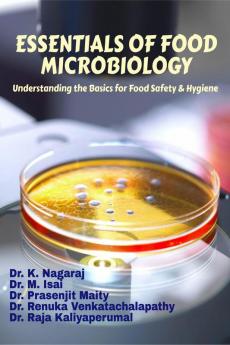
ESSENTIALS OF FOOD MICROBIOLOGY : Understanding the Basics for Food Safety & Hygiene

by
Dr. K. Nagaraj Dr. Isai Mathivanan Dr. Prasenjit Maity Dr. Renuga VenkatachalaDr. Raja Kaliyaperumal
English
Paperback
₹264
₹300
12% OFF
(All inclusive*)
Delivery Options
Please enter pincode to check delivery time.
*COD & Shipping Charges may apply on certain items.
Review final details at checkout.
Looking to place a bulk order? SUBMIT DETAILS
About The Book
Description
Author
<p>Essentials of Food Microbiology is an indispensable guide that provides a comprehensive overview of the principles practices and applications of microbiology in the context of food safety and quality. Written by leading experts in the field this book offers a thorough exploration of the microbial world as it relates to the production processing distribution and consumption of food. Starting with an introduction to the fundamentals of microbiology including microbial structure metabolism and growth the book swiftly progresses to cover topics such as microbial diversity foodborne pathogens spoilage organisms and beneficial microbes. Each chapter is meticulously crafted to offer a balanced blend of theoretical insights and practical applications making it an ideal resource for students researchers and professionals alike.</p>
Delivery Options
Please enter pincode to check delivery time.
*COD & Shipping Charges may apply on certain items.
Review final details at checkout.
Details
ISBN 13
9798893225136
Publication Date
-25-03-2024
Pages
-114
Weight
-288 grams
Dimensions
-215.9x279.4x6.46 mm